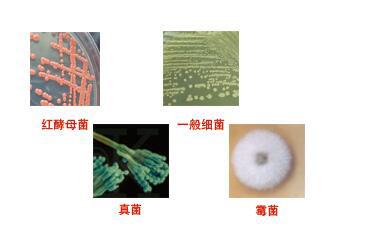
(BUCSAV 162, CCM 1459, NCIB 8158, NCTC 10343, NRS 1105)

菌种的培养:
1、菌种是指食用菌菌丝体及其生长基质组成的繁殖材料。菌种分为母种(一级种)、原种(二级种)和栽培种(三级种)三级。工业发酵的有用菌种,其筛选步骤包括菌种分离、初筛和复筛。
2、挑选具有某种能力的有用菌种,也称种子制备,是指菌种在一定条件下,经过扩大培养成为具有一定数量和质量的纯生产菌种的制备过程。以作接入发酵罐中进一步扩大菌体量及合成产物之用。
3、种子制备包括孢子制备和菌丝体制备 菌种制备。
4、保存在沙土管或冷冻管中的生产菌种,用无菌手续挑取少许,接入琼脂斜面培养基上,在25℃(或较高温度)下培养5~7天(或较长时间。所得孢子还需进一步用较大表面积的固体培养基以获得更多孢子(对于霉菌类孢子制备,多数采用大米、小米之类的天然培养基)。
5、将培养成熟的斜面孢子制成悬浮液,接种到扁瓶固体培养基上,于25~28℃培养14天。将成熟的扁瓶孢子于真空中抽干,使水分降至10%以下,并放入 4℃冰箱中备用。一次制得的孢子瓶可在生产上延续使用半年左右。
6、如果有些生产菌种不产孢子,如赤霉素产生菌或产孢子不多的,则可采用摇瓶液体培养制得菌丝体,作种子罐的种子。种子罐的目的是使接入有限的孢子或菌丝体迅速发芽、生长、繁殖成大量菌体。其中的培养基组分应是易于被菌体利用的碳源(如葡萄糖)和氮源(如玉米浆),及无机盐(如磷酸盐)等。作为发酵罐的种子应生命力旺盛、染色深、菌丝粗壮,无杂菌及异常菌体。接种量一般在10%~20%。
产品名称:[BUCSAV 162, CCM 1459, NCIB
8158, NCTC 10343, NRS 1105]
拉丁文: Paenibacillus
polymyxa (Prazmowski) Ash et al.
提供形式: freeze-dried
安全等级: 1
模式菌株: yes
应用领域: Quality control
Biotechnology
培养基: Medium 3: Nutrient agar or nutrient broth
生长条件: Temperature: 30°C
Atmosphere: Aerobic
|
产品名称 |
英文名称 |
货号 |
|
[BUCSAV 162, CCM 1459, NCIB 8158, NCTC 10343, NRS 1105] |
Paenibacillus polymyxa (Prazmowski) Ash et al. |
FS-J63693 |
我司代理ATCC菌种,竭诚为大中型科研提供严格质量体系控制ATCC,CMCC,CICC,DSMZ标准菌株。产品仅用于科研.批量订购可享受价格优惠,我司可提供完整的售前、售中和售后服务。
菌种的使用范围:
(1)合成培养基。合成培养基的各种成分完全是已知的各种化学物质。这种培养基的化学成分清楚,酿酒酵母菌组成成分,重复性强,而且微生物在这类培养基中生长较慢。如高氏一号合成培养基、察氏(Czapek)培养基等。
(2)天然培养基。由天然物质制成,如蒸熟的马铃薯和普通牛肉汤,前者用于培养霉菌,后者用于培养细菌。这类培养基的化学成分很不恒定,也难以确定,但配制方便,营养丰富,培养效果好,所以常被采用。
(3)半合成培养基。在天然有机物的基础上适当加入已知成分的无机盐类,或在合成培养基的基础上添加某些天然成分,如培养霉菌用的马铃薯葡萄糖琼脂培养基。这类培养基能更有效地满足微生物对营养物质的需要。
保藏方法:
1. 传代培养保藏法
又有斜面培养、穿刺培养、疱肉培养基培养等(后者作保藏厌氧细菌用),培养后于4-6℃冰箱内保存。
2. 液体石蜡覆盖保藏法
是传代培养的变相方法,能够适当延长保藏时间,它是在斜面培养物和穿刺培养物上面覆盖灭菌的液体石蜡,一方面可防止因培养基水分蒸发而引起菌种死亡,另一方面可阻止氧气进入,以减弱代谢作用。
3. 载体保藏法
是将微生物吸附在适当的载体,如土壤、沙子、硅胶、滤纸上,而后进行干燥的保藏法,例如沙土保藏法和滤纸保藏法应用相当广泛。
4. 寄主保藏法
用于目前尚不能在人工培养基上生长的微生物,如病毒、立克次氏体、螺旋体等,它们必须在生活的动物、昆虫、鸡胚内感染并传代,此法相当于一般微生物的传代培养保藏法。病毒等微生物亦可用其他方法如液氮保藏法与冷冻干燥保藏法进行保藏。
5. 冷冻保藏法可分低温冰箱(-20-30℃,-50-80℃)、干冰酒精快速冻结(约-70℃)和液氮(-196℃)等保藏法
保藏方法:
1.传代培养保藏法
公司产品仅用于科研又有斜面培养、穿刺培养、疱肉培养基培养等(后者作保藏厌氧细菌用),培养后于4-6℃冰箱内保存。
2. 液体石蜡覆盖保藏法
是传代培养的变相方法,能够适当延长保藏时间,它是在斜面培养物和穿刺培养物上面覆盖灭菌的液体石蜡,一方面可防止因培养基水分蒸发而引起菌种死亡,另一方面可阻止氧气进入,以减弱代谢作用。
3. 载体保藏法
是将微生物吸附在适当的载体,如土壤、沙子、硅胶、滤纸上,而后进行干燥的保藏法,例如沙土保藏法和滤纸保藏法应用相当广泛。
4. 寄主保藏法
用于目前尚不能在人工培养基上生长的微生物,如病毒、立克次氏体、螺旋体等,它们必须在生活的动物、昆虫、鸡胚内感染并传代,此法相当于一般微生物的传代培养保藏法。病毒等微生物亦可用其他方法如液氮保藏法与冷冻干燥保藏法进行保藏。
5. 冷冻保藏法
可分低温冰箱(-20-30℃,-50-80℃)、干冰酒精快速冻结(约-70℃)和液氮(-196℃)等保藏法。
6. 冷冻干燥保藏法
先使微生物在极低温度(-70℃左右)下快速冷冻,然后在减压下利用升华现象除去水分(真空干燥)。有些方法如滤纸保藏法、液氮保藏法和冷冻干燥保藏法等均需使用保护剂来制备细胞悬液,以防止因冷冻或水分不断升华对细胞的损害。保护性溶质可通过氢和离子键对水和细胞所产生的亲和力来稳定细胞成分的构型。保护剂有牛乳、血清、糖类、甘油、二甲亚砜等。
胰腺导管上皮细胞Many types of cells包装:5 × 105方(1ml)8-氟-6-甲氧基莫西沙星质量规格:美国进口8-Fluoro-6-methoxy Moxifloxacin
EFNB2A Others Danio rerio (zebrafish) 斑马鱼 EFNB2A / Ephrin B2a 细胞裂解液 (阳性对照) (R)-酰基萘普生-β-D-葡萄糖苷酸苄基酯质量规格:美国进口(R)-Naproxen Acyl-β-D-glucuronide Benzyl Ester
大鼠肾上腺嗜铬细胞瘤细胞;PC-12 [PC12](S)-酰基萘普生-β-D-葡萄糖苷酸苄基酯质量规格:美国进口(S)-Naproxen Acyl-β-D-glucuronide Benzyl Ester
MRC-5细胞,胚肺细胞 大鼠肺上皮Ⅱ型细胞,RLE-6TN细胞 T-109B弹性蛋白酶(含100mL酶解缓冲液)10mL(R)-O-去甲基萘普生质量规格:美国进口(R)-O-Desmethyl Naproxen
SK-OV-3(卵巢癌细胞) 5×106cells/瓶×2莫沙必利质量规格:美国进口Mosapride
药典培养基(05药典)
CSF2 Others Mouse 小鼠 GM-CSF / CSF2 人细胞裂解液 (阳性对照)
CD86 Others Mouse 小鼠 CD86 / B7-2 细胞裂解液 (阳性对照) 醋酸磺胺米隆Mafenide Acetate质量规格:>98%,BR
结膜成纤维细胞cDNAHConF cDNA硼替佐米中间体IBortezomib intermediates I质量规格:>97%
IL6ST Others Rat 大鼠 gp130 / IL6ST / CD130 细胞裂解液 (阳性对照) 保特佐米蒎烷二醇酯BortezoMib Pinanediol Ester质量规格:>97%
293 胚肾细胞甲磺司特Suplatast tosilate质量规格:>98%,BR
CL-0281HELF(胚肺成纤维细胞)5×106cells/瓶×21丙基-α-D-吡喃半乳糖苷Allyl α-D-galactopyranoside质量规格:>97%,BR
白色念珠菌CMCC98001冻干粉
鲁氏接合酵母
贝酵母 类红红细菌
粟褐芽孢杆菌 灰色链霉菌
温特曲霉 醋酸菌
肠炎沙门氏菌亚利桑那亚种
停乳链球菌 ATCC 35666
[BUCSAV 162, CCM 1459, NCIB 8158, NCTC 10343, NRS 1105]培养及打管说明:
1、安瓿瓶开封:用浸过75%酒精的脱脂棉擦净安瓿管,用火焰加热其顶端,滴少量无菌水至加热顶端使之破裂,用锉刀或者镊子敲下已破裂的安瓿管顶端。
2、菌株恢复培养:用无菌吸管吸取0.3--0.5ml适宜的液体培养基,滴入安瓿管内,轻轻振荡,使冻干菌体溶解呈悬浮状。吸取全部菌体悬浮液,移植于1-2支建议的培养基试管中,并在建议的条件下培养。
3、注意事项:菌种活化前,请将安瓿管保存在6-10℃的环境下,某些菌种经过冷冻干燥保存后,延迟期较长,需要连续两次继代培养才能正常生长
4、复苏后的菌种在传1-2代后使用。
5、暂不启开的安瓿及复苏后需保藏的斜面应于4℃中保藏。